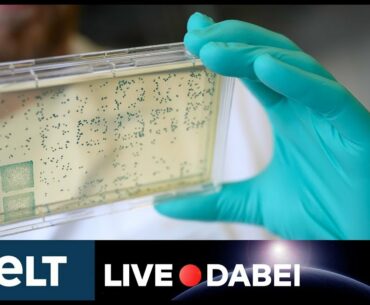
KAMPF GEGEN CORONAVIRUS: Altmaier zum Corona-Impfstoff-Deal und der Beteiligung an CureVac

Was ist dran wirklich dran: Hilft uns Vitamin D tatsächlich beim Kampf gegen Covid 19? Wir checken mit Internist Tilo Hanfstingl die Fakten. 🔔Hier unseren Kanal abonnieren um keine Infos aus Hessen zu verpassen: ▬▬▬▬▬▬▬▬▬▬▬▬▬▬▬ 📺Mehr aktuelle Inhalte des Hessischen…